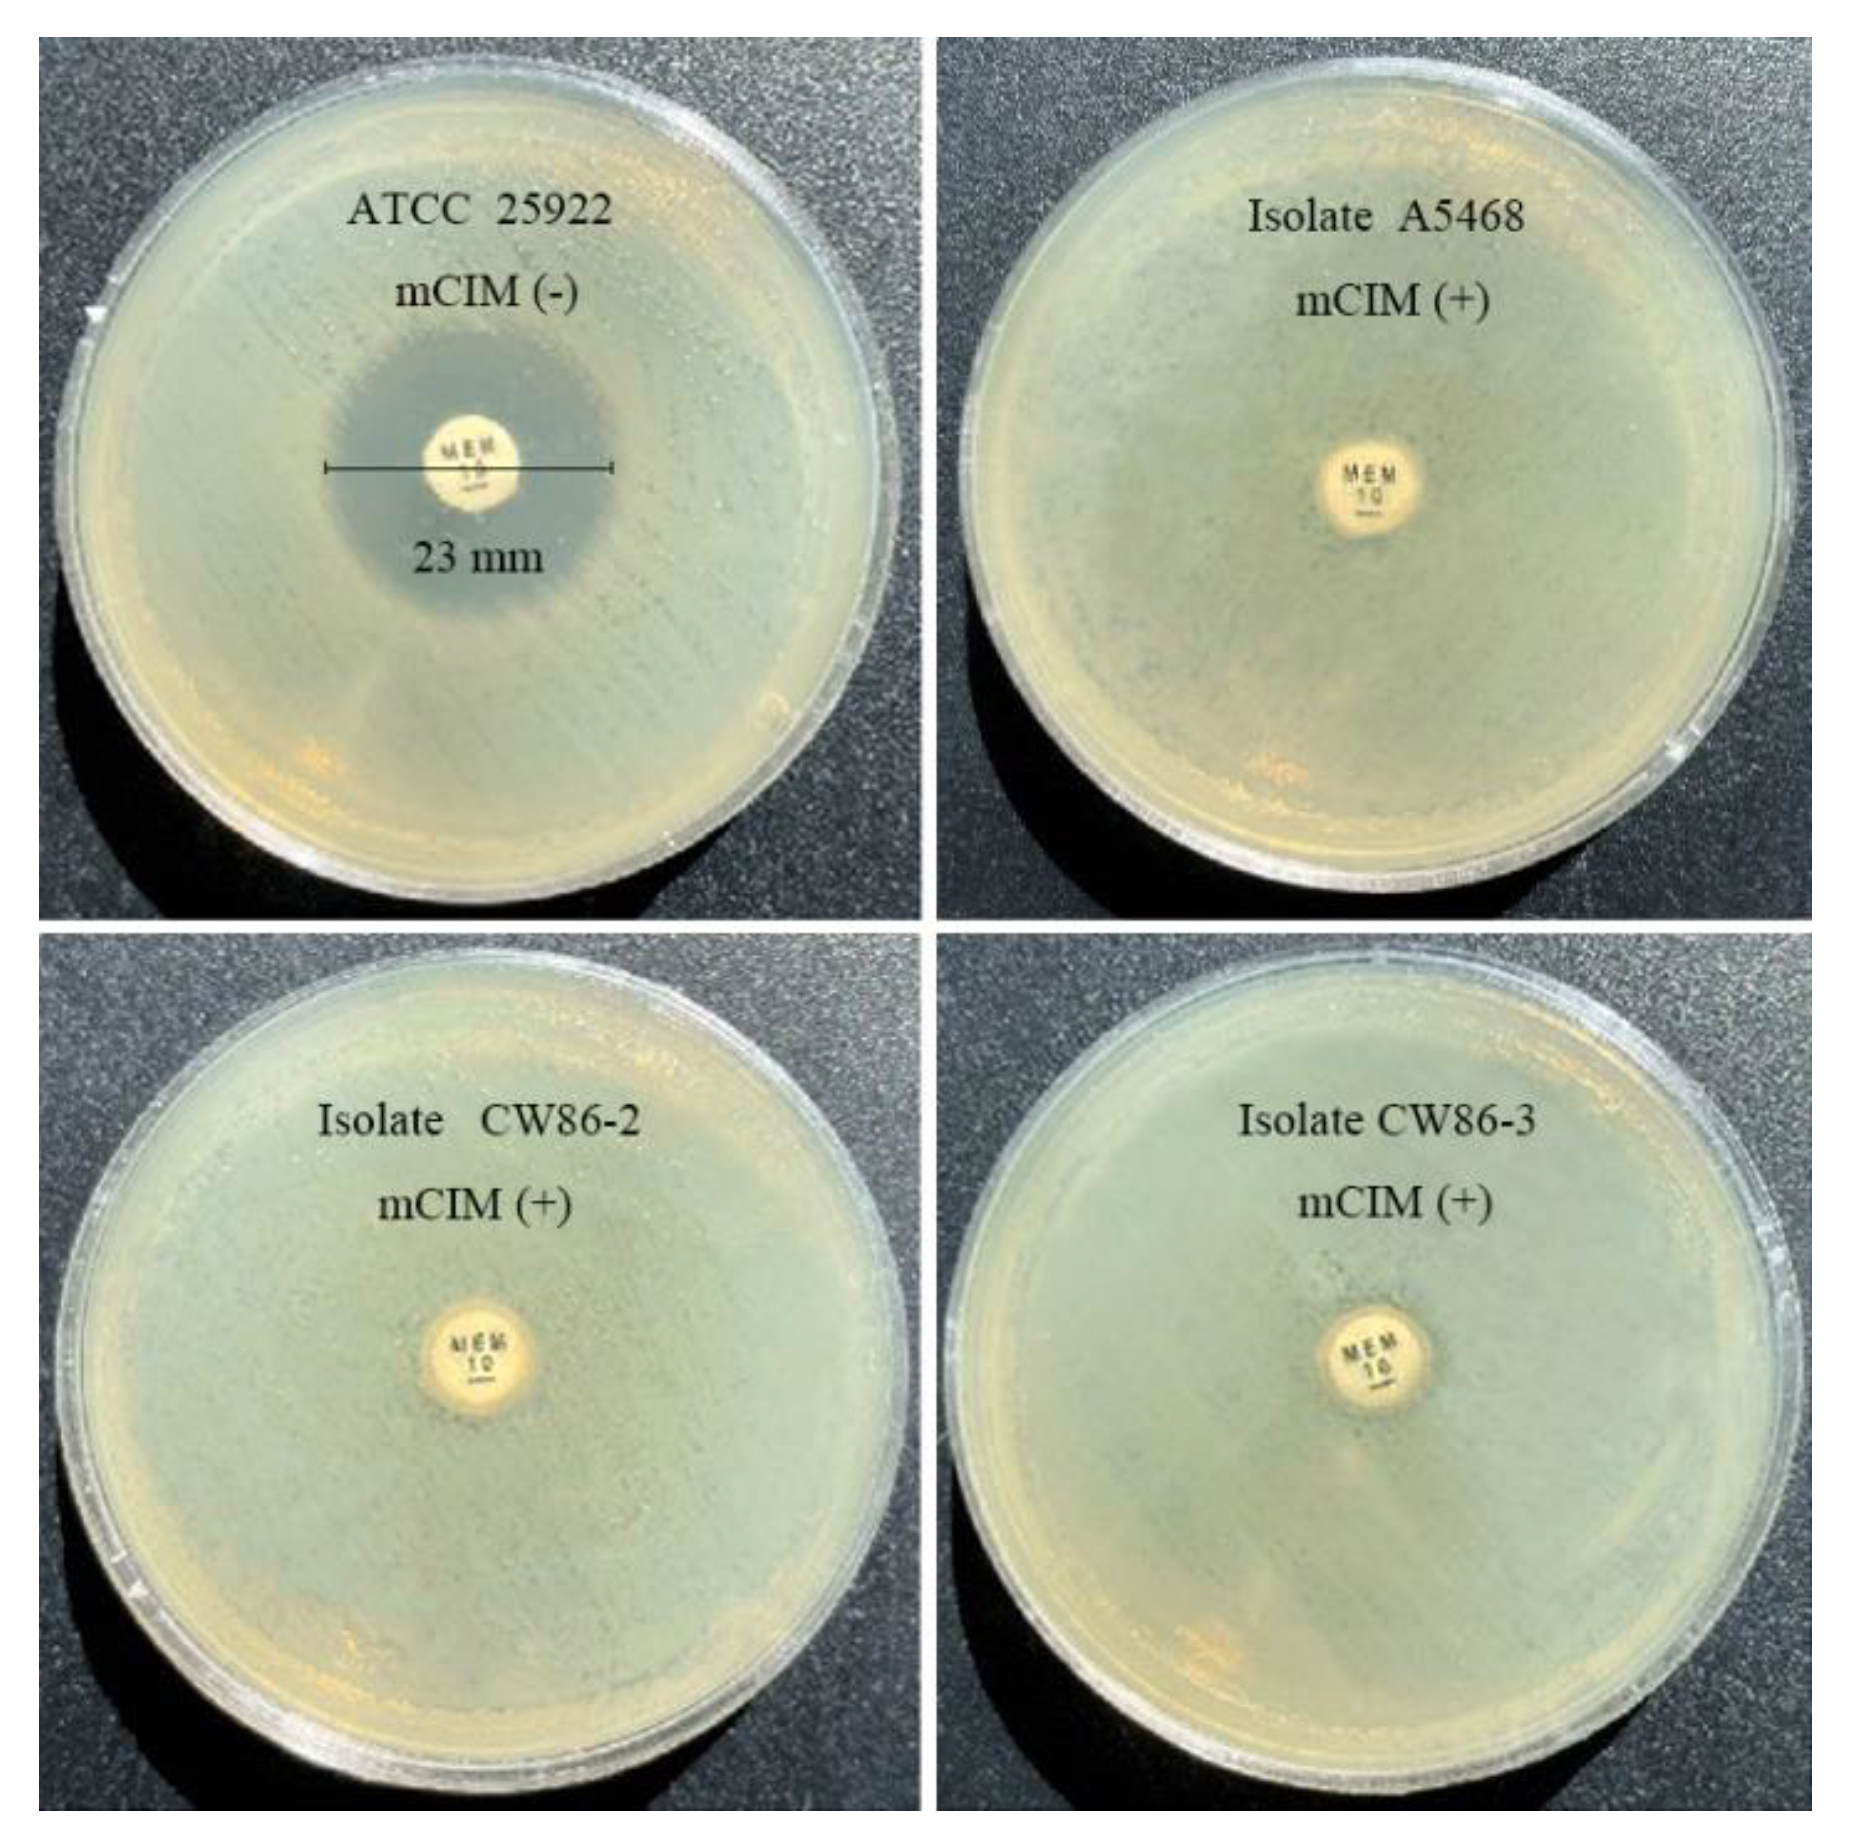

Unveiling the Emergence and Genetic Diversity of OXA-48-like Carbapenemase Variants in Shewanella xiamenensis
Abstract
1. Introduction
2. Materials and Methods
2.1. Strain Collection and Identification
2.2. Antimicrobial Susceptibility Testing
2.3. Phenotypic Profiles of Isolates
2.4. Whole-Genome Sequencing and Phylogenetic Analyses
2.5. Cloning and Functional Verification of BlaOXA Genes
2.6. β–Lactamase Activity Assay
3. Results
3.1. Species Isolation and Identification
3.2. Antimicrobial Profile of Isolates
3.3. Phenotypic Detection of Carbapenemase-Producing S. xiamenensis
3.4. Phylogenetic Analysis and Genetic Characterization of Strains
3.5. Hydrolytic Spectra of OXA-48-like-Carrying Cloning Strains
3.6. Purification and Biochemical Properties of OXA-Type Carbapenemase
4. Discussion
5. Conclusions
Author Contributions
Funding
Data Availability Statement
Acknowledgments
Conflicts of Interest
References
- Nordmann, P.; Dortet, L.; Poirel, L. Carbapenem resistance in Enterobacteriaceae: Here is the storm! Trends Mol. Med. 2012, 18, 263–272. [Google Scholar] [CrossRef] [PubMed]
- Yoon, E.; Jeong, S.H. Class D β-lactamases. J. Antimicrob. Chemother. 2021, 76, 836–864. [Google Scholar] [CrossRef] [PubMed]
- Bush, K. Past and Present Perspectives on β-Lactamases. Antimicrob. Agents Chemother. 2018, 62, e01076-18. [Google Scholar] [CrossRef] [PubMed]
- Ambler, R.P. The structure of beta-lactamases. Philos. Trans. R. Soc. B Biol. Sci. 1980, 289, 321–331. [Google Scholar] [CrossRef]
- Naas, T.; Oueslati, S.; Bonnin, R.A.; Dabos, M.L.; Zavala, A.; Dortet, L.; Retailleau, P.; Iorga, B.I. Beta-lactamase database (BLDB)—Structure and function. J. Enzym. Inhib. Med. Chem. 2017, 32, 917–919. [Google Scholar] [CrossRef] [PubMed]
- Nordmann, P.; Poirel, L. Epidemiology and Diagnostics of Carbapenem Resistance in Gram-negative Bacteria. Clin. Infect. Dis. 2019, 69, S521–S528. [Google Scholar] [CrossRef]
- Muñoz-Gallego, I.; Chaves, F.; Orellana, M.A. Epidemiological and clinical characteristics of Shewanella spp. infections in a tertiary hospital in Madrid. Infect. Dis. 2016, 48, 760–762. [Google Scholar] [CrossRef]
- Wang, J.; Tseng, S.; Tung, K. Genomic investigation of emerging zoonotic pathogen Shewanella xiamenensis. Tzu Chi Med. J. 2020, 32, 162. [Google Scholar] [CrossRef]
- Yousfi, K.; Bekal, S.; Usongo, V.; Touati, A. Current trends of human infections and antibiotic resistance of the genus Shewanella. Eur. J. Clin. Microbiol. Infect. Dis. 2017, 36, 1353–1362. [Google Scholar] [CrossRef]
- Yu, K.; Huang, Z.; Xiao, Y.; Wang, D. Shewanella infection in humans: Epidemiology, clinical features and pathogenicity. Virulence 2022, 13, 1515–1532. [Google Scholar] [CrossRef]
- Ohama, Y.; Aoki, K.; Harada, S.; Nagasawa, T.; Sawabe, T.; Nonaka, L.; Moriya, K.; Ishii, Y.; Tateda, K. Genetic Environment Surrounding blaOXA-55-like in Clinical Isolates of Shewanella algae Clade and Enhanced Expression of blaOXA-55-like in a Carbapenem-Resistant Isolate. Msphere 2021, 6, e00593-21. [Google Scholar] [CrossRef] [PubMed]
- Tacão, M.; Araújo, S.; Vendas, M.; Alves, A.; Henriques, I. Shewanella species as the origin of blaOXA-48 genes: Insights into gene diversity, associated phenotypes and possible transfer mechanisms. Int. J. Antimicrob. Agents 2018, 51, 340–348. [Google Scholar] [CrossRef] [PubMed]
- Ceccarelli, D.; van Essen-Zandbergen, A.; Veldman, K.T.; Tafro, N.; Haenen, O.; Mevius, D.J. Chromosome-Based blaOXA-48-Like Variants in Shewanella Species Isolates from Food-Producing Animals, Fish, and the Aquatic Environment. Antimicrob. Agents Chemother. 2017, 61, e01013-16. [Google Scholar] [CrossRef] [PubMed]
- Ibrahim, N.N.N.; Nasir, N.M.; Sahrani, F.K.; Ahmad, A.; Sairi, F. Characterization of putative pathogenic Shewanella algae isolated from ballast water. Vet. World 2021, 14, 678–688. [Google Scholar] [CrossRef]
- Nguyen, N.T.; Takemura, T.; Pham, A.H.Q.; Tran, H.T.; Vu, K.C.T.; Tu, N.D.; Huong, L.T.; Cuong, N.T.; Kasuga, I.; Hasebe, F.; et al. Whole-genome sequencing and comparative genomic analysis of Shewanella xiamenensis strains carrying blaOXA-48-like genes isolated from water environment in Vietnam. J. Glob. Antimicrob. Resist. 2020, 21, 272–274. [Google Scholar] [CrossRef]
- Tacão, M.; Correia, A.; Henriques, I. Environmental Shewanella xiamenensis strains that carry blaOXA-48 or blaOXA-204 genes: Additional proof for blaOXA-48-like gene origin. Antimicrob. Agents Chemother. 2013, 57, 6399–6400. [Google Scholar] [CrossRef]
- Zou, H.; Zhou, Z.; Xia, H.; Zhao, Q.; Li, X. Characterization of Chromosome-Mediated BlaOXA-894 in Shewanella xiamenensis Isolated from Pig Wastewater. Int. J. Environ. Res. Public Health 2019, 16, 3768. [Google Scholar] [CrossRef]
- Antonelli, A.; Di Palo, D.M.; Galano, A.; Becciani, S.; Montagnani, C.; Pecile, P.; Galli, L.; Rossolini, G.M. Intestinal carriage of Shewanella xiamenensis simulating carriage of OXA-48–producing Enterobacteriaceae. Diagn. Microbiol. Infect. Dis. 2015, 82, 1–3. [Google Scholar] [CrossRef]
- Benaissa, E.; Abassor, T.; Oucharqui, S.; Maleb, A.; Elouennass, M. Shewanella putrefaciens: A cause of bacteremia not to neglect. Idcases 2021, 26, e1294. [Google Scholar] [CrossRef]
- Cimmino, T.; Olaitan, A.O.; Rolain, J.M. Whole genome sequence to decipher the resistome of Shewanella algae, a multidrug-resistant bacterium responsible for pneumonia, Marseille, France. Expert Rev. Anti-Infect. Ther. 2016, 14, 269–275. [Google Scholar] [CrossRef]
- Lemaire, O.N.; Mejean, V.; Iobbi-Nivol, C. The Shewanella genus: Ubiquitous organisms sustaining and preserving aquatic ecosystems. FEMS Microbiol. Rev. 2020, 44, 155–170. [Google Scholar] [CrossRef] [PubMed]
- Wu, Z.; Ho, S.; Cheng, J.; Tung, K.; Hong, Y.; Chen, S.; Menzer, A.; Chen, Y.; Huang, Y.; Liu, P. Whole-genome characterization of Shewanella algae strain SYT3 isolated from seawater reveals insight into hemolysis. Future Microbiol. 2018, 13, 1709–1717. [Google Scholar] [CrossRef] [PubMed]
- Huang, Y.T.; Cheng, J.F.; Wu, Z.Y.; Tung, K.C.; Chen, Y.J.; Hong, Y.K.; Chen, S.Y.; Liu, P.Y. Genomic and phylogenetic characterization of Shewanella xiamenensis isolated from giant grouper (Epinephelus lanceolatus) in Taiwan. Zoonoses Public Health 2019, 66, 679–685. [Google Scholar] [CrossRef]
- Ainoda, Y.; Tanaka, E.; Wajima, T.; Nakaminami, H.; Hirota, Y.; Matsushita, T.; Hirai, Y. A case of Shewanella algae-induced bacteremia in Japan: Case report and literature review. J. Infect. Chemother. 2022, 28, 1430–1432. [Google Scholar] [CrossRef] [PubMed]
- Muller, S.; von Bonin, S.; Schneider, R.; Kruger, M.; Quick, S.; Schrottner, P. Shewanella putrefaciens, a rare human pathogen: A review from a clinical perspective. Front. Cell. Infect. Microbiol. 2022, 12, 1033639. [Google Scholar] [CrossRef] [PubMed]
- Huang, J.; Sun, B.; Zhang, X. Shewanella xiamenensis sp. nov., isolated from coastal sea sediment. Int. J. Syst. Evol. Microbiol. 2010, 60, 1585–1589. [Google Scholar] [CrossRef]
- Laurent, P.; Claire, H.; Patrice, N. Chromosome-Encoded Ambler Class D β-Lactamase of Shewanella oneidensis as a Progenitor of Carbapenem-Hydrolyzing Oxacillinase. Antimicrob. Agents Chemother. 2004, 48, 348–351. [Google Scholar] [CrossRef]
- Ramsamy, Y.; Mlisana, K.P.; Amoako, D.G.; Abia, A.; Ismail, A.; Allam, M.; Mbanga, J.; Singh, R.; Essack, S.Y. Mobile genetic elements-mediated Enterobacterales-associated carbapenemase antibiotic resistance genes propagation between the environment and humans: A One Health South African study. Sci. Total Environ. 2022, 806, 150641. [Google Scholar] [CrossRef]
- Van Duin, D.; Doi, Y. The global epidemiology of carbapenemase-producing Enterobacteriaceae. Virulence 2017, 8, 460–469. [Google Scholar] [CrossRef]
- Cunningham, S.A.; Limbago, B.; Traczewski, M.; Anderson, K.; Hackel, M.; Hindler, J.; Sahm, D.; Alyanak, E.; Lawsin, A.; Gulvik, C.A.; et al. Multicenter Performance Assessment of Carba NP Test. J. Clin. Microbiol. 2017, 55, 1954–1960. [Google Scholar] [CrossRef]
- Pierce, V.M.; Simner, P.J.; Lonsway, D.R.; Roe-Carpenter, D.E.; Johnson, J.K.; Brasso, W.B.; Bobenchik, A.M.; Lockett, Z.C.; Charnot-Katsikas, A.; Ferraro, M.J.; et al. Modified Carbapenem Inactivation Method for Phenotypic Detection of Carbapenemase Production among Enterobacteriaceae. J. Clin. Microbiol. 2017, 55, 2321–2333. [Google Scholar] [CrossRef] [PubMed]
- Iovleva, A.; Doi, Y. Carbapenem-Resistant Enterobacteriaceae. Clin. Lab. Med. 2017, 37, 303–315. [Google Scholar] [CrossRef] [PubMed]
- Li, Y.; Ng, I.S.; Zhang, X.; Wang, N. Draft Genome Sequence of the Dye-Decolorizing and Nanowire-Producing Bacterium Shewanella xiamenensis BC01. Genome Announc. 2014, 2, e00721-14. [Google Scholar] [CrossRef] [PubMed]
- Samuelsen, Ø.; Hansen, F.; Aasnæs, B.; Hasman, H.; Lund, B.A.; Leiros, H.S.; Lilje, B.; Janice, J.; Jakobsen, L.; Littauer, P.; et al. Dissemination and Characteristics of a Novel Plasmid-Encoded Carbapenem-Hydrolyzing Class D β-Lactamase, OXA-436, Found in Isolates from Four Patients at Six Different Hospitals in Denmark. Antimicrob. Agents Chemother. 2018, 62, e01260-17. [Google Scholar] [CrossRef] [PubMed]
- Shanmugakani, R.K.; Sugawara, Y.; Akeda, Y.; Hagiya, H.; Sakamoto, N.; Aye, M.M.; Myint, T.; Hamada, S.; Tomono, K. blaOXA-731, a new chromosome-encoded blaOXA-48-like variant in Shewanella sp. from the aquatic environment in Myanmar. Environ. Microbiol. Rep. 2020, 12, 548–554. [Google Scholar] [CrossRef]
- Poirel, L.; Potron, A.; Nordmann, P. OXA-48-like carbapenemases: The phantom menace. J. Antimicrob. Chemother. 2012, 67, 1597–1606. [Google Scholar] [CrossRef]
- Dabos, L.; Jousset, A.B.; Bonnin, R.A.; Fortineau, N.; Zavala, A.; Retailleau, P.; Iorga, B.I.; Naas, T. Genetic and Biochemical Characterization of OXA-535, a Distantly Related OXA-48-Like β-Lactamase. Antimicrob. Agents Chemother. 2018, 62, e01198-18. [Google Scholar] [CrossRef]
- Wang, L.J.; Fan, Y.Y.; Wang, M.; Lu, X.X. Detection of carbapenem-producing Enterobacteriaceae by MALDI-TOF MS. Zhonghua Yi Xue Za Zhi 2013, 93, 2079–2081. [Google Scholar]
- Rotova, V.; Papagiannitsis, C.C.; Skalova, A.; Chudejova, K.; Hrabak, J. Comparison of imipenem and meropenem antibiotics for the MALDI-TOF MS detection of carbapenemase activity. J. Microbiol. Methods 2017, 137, 30–33. [Google Scholar] [CrossRef]
- Wilhelm, C.M.; Forni, G.D.R.; Carneiro, M.D.S.; Barth, A.L. Establishing a quantitative index of meropenem hydrolysis for the detection of KPC- and NDM-producing bacteria by MALDI-TOF MS. J. Microbiol. Methods 2021, 187, 106268. [Google Scholar] [CrossRef]
- Hrabak, J.; Studentova, V.; Bergerova, T.; Walkova, R.; Zemlickova, H.; Jakubu, V.; Chudackova, E.; Gniadkowski, M.; Pfeifer, Y.; Perry, J.D.; et al. Detection of NDM-1, VIM-1, KPC, OXA-48, and OXA-162 Carbapenemases by Matrix-Assisted Laser Desorption Ionization–Time of Flight Mass Spectrometry. J. Clin. Microbiol. 2012, 50, 2441–2443. [Google Scholar] [CrossRef] [PubMed]
- Tafoukt, R.; Leangapichart, T.; Hadjadj, L.; Bakour, S.; Diene, S.M.; Rolain, J.; Touati, A. Characterisation of blaOXA-538, a new variant of blaOXA-48, in Shewanella xiamenensis isolated from river water in Algeria. J. Glob. Antimicrob. Resist. 2018, 13, 70–73. [Google Scholar] [CrossRef] [PubMed]
- Brilhante, M.; Menezes, J.; Belas, A.; Feudi, C.; Schwarz, S.; Pomba, C.; Perreten, V. OXA-181-Producing Extraintestinal Pathogenic Escherichia coli Sequence Type 410 Isolated from a Dog in Portugal. Antimicrob. Agents Chemother. 2020, 64, e02298-19. [Google Scholar] [CrossRef] [PubMed]
- Janda, J.M.; Abbott, S.L. The genus Shewanella: From the briny depths below to human pathogen. Crit. Rev. Microbiol. 2014, 40, 293–312. [Google Scholar] [CrossRef]
- Yousfi, K.; Touati, A.; Lefebvre, B.; Fournier, É.; Côté, J.; Soualhine, H.; Walker, M.; Bougdour, D.; Tremblay, C.; Bekal, S. A Novel Plasmid, pSx1, Harboring a New Tn1696 Derivative from Extensively Drug-Resistant Shewanella xiamenensis Encoding OXA-416. Microb. Drug Resist. 2017, 23, 429–436. [Google Scholar] [CrossRef]
- Zago, V.; Veschetti, L.; Patuzzo, C.; Malerba, G.; Lleo, M.M. Resistome, Mobilome and Virulome Analysis of Shewanella algae and Vibrio spp. Strains Isolated in Italian Aquaculture Centers. Microorganisms 2020, 8, 572. [Google Scholar] [CrossRef]
- Wen, Y.; Xie, X.; Xu, P.; Yang, C.; Zhu, Z.; Zhu, J.; Lv, J.; Zhang, H.; Chen, L.; Du, H. NDM-1 and OXA-48-Like Carbapenemases (OXA-48, OXA-181 and OXA-252) Co-Producing Shewanella xiamenensis from Hospital Wastewater, China. Infect. Drug Resist. 2022, 15, 6927–6938. [Google Scholar] [CrossRef]
- Fang, Y.; Wang, Y.; Liu, Z.; Lu, B.; Dai, H.; Kan, B.; Wang, D. Shewanella carassii sp. nov., isolated from surface swabs of crucian carp and faeces of a diarrhoea patient. Int. J. Syst. Evol. Microbiol. 2017, 67, 5284–5289. [Google Scholar] [CrossRef]
- Araujo, S.; Azenha, S.R.; Henriques, I.; Tacao, M. qnrA gene diversity in Shewanella spp. Microbiology 2021, 167, 001118. [Google Scholar] [CrossRef]
- Da, C.W.; Giambiagi-Demarval, M.; Laport, M.S. Shewanella harboring antimicrobial and copper resistance genes in sea urchins (Paracentrotus lividus) from the Crozon peninsula (Brittany, France). Infect. Genet. Evol. 2020, 85, 104437. [Google Scholar] [CrossRef]
- Jousset, A.B.; Dabos, L.; Bonnin, R.A.; Girlich, D.; Potron, A.; Cabanel, N.; Dortet, L.; Glaser, P.; Naas, T. CTX-M-15-Producing Shewanella Species Clinical Isolate Expressing OXA-535, a Chromosome-Encoded OXA-48 Variant, Putative Progenitor of the Plasmid-Encoded OXA-436. Antimicrob. Agents Chemother. 2018, 62, e01879-17. [Google Scholar] [CrossRef] [PubMed]
- Rivera-Izquierdo, M.; Láinez-Ramos-Bossini, A.J.; Rivera-Izquierdo, C.; López-Gómez, J.; Fernández-Martínez, N.F.; Redruello-Guerrero, P.; Martín-Delosreyes, L.M.; Martínez-Ruiz, V.; Moreno-Roldán, E.; Jiménez-Mejías, E. OXA-48 Carbapenemase-Producing Enterobacterales in Spanish Hospitals: An Updated Comprehensive Review on a Rising Antimicrobial Resistance. Antibiotics 2021, 10, 89. [Google Scholar] [CrossRef] [PubMed]

| Antimicrobial Agent | MIC (μg/mL) | ||
|---|---|---|---|
| S. xiamenensis A5468 | S. xiamenensis CW86-2 | S. xiamenensis CW86-3 | |
| Ampicillin | <=2 | <=2 | <=2 |
| Ampicillin-Sulbactam | 2/1 | 2/1 | <=1/0.5 |
| Aztreonam | 2 | 1 | 0.5 |
| Cefotaxime | 1 | <=0.25 | <=0.25 |
| Cefoxitin | 4 | <=2 | <=2 |
| Ceftazidime | 4 | 0.5 | 1 |
| Ceftazidime-Avibactam | <=0.25/4 | <=0.25/4 | <=0.25/4 |
| Chloramphenicol | 16 | <=4 | <=4 |
| Ciprofloxacin | >2 | >2 | >2 |
| Ertapenem | 4 | 4 | 2 |
| Imipenem | 2 | 1 | 1 |
| Meropenem | 1 | 1 | 0.5 |
| Tetracycline | <=1 | 2 | >16 |
| Isolate | MICs (μg/mL) a | ||||||||
|---|---|---|---|---|---|---|---|---|---|
| AMP | AMS | ATM | CTX | FOX | CAZ | ETM | IMP | MEM | |
| BL21(pET30a-OXA-181) | 4 | 2/1 | 1 | <=0.25 | <=2 | <=0.25 | <=0.25 | 1 | 0.5 |
| BL21 (pET30a-OXA-1038) | <=2 | 2/1 | <=0.25 | <=0.25 | <=2 | <=0.25 | <=0.25 | 1 | 0.5 |
| BL21 (pET30a-OXA-1039) | <=2 | <=1/0.5 | <=0.25 | <=0.25 | <=2 | <=0.25 | <=0.25 | 1 | <=0.125 |
| BL21 (pET30a) | <=2 | <=1/0.5 | <=0.25 | <=0.25 | <=2 | <=0.25 | <=0.25 | 0.5 | <=0.125 |
| BL21 (DE3) | <=2 | <=1/0.5 | <=0.25 | <=0.25 | <=2 | <=0.25 | <=0.25 | 0.5 | <=0.125 |
Disclaimer/Publisher’s Note: The statements, opinions and data contained in all publications are solely those of the individual author(s) and contributor(s) and not of MDPI and/or the editor(s). MDPI and/or the editor(s) disclaim responsibility for any injury to people or property resulting from any ideas, methods, instructions or products referred to in the content. |
© 2023 by the authors. Licensee MDPI, Basel, Switzerland. This article is an open access article distributed under the terms and conditions of the Creative Commons Attribution (CC BY) license (https://creativecommons.org/licenses/by/4.0/).
Share and Cite
Jiang, X.; Miao, B.; Zhao, X.; Bai, X.; Yuan, M.; Chen, X.; Gong, X.; Liu, Z.; Li, J.; Meng, S.; et al. Unveiling the Emergence and Genetic Diversity of OXA-48-like Carbapenemase Variants in Shewanella xiamenensis. Microorganisms 2023, 11, 1325. https://doi.org/10.3390/microorganisms11051325
Jiang X, Miao B, Zhao X, Bai X, Yuan M, Chen X, Gong X, Liu Z, Li J, Meng S, et al. Unveiling the Emergence and Genetic Diversity of OXA-48-like Carbapenemase Variants in Shewanella xiamenensis. Microorganisms. 2023; 11(5):1325. https://doi.org/10.3390/microorganisms11051325
Chicago/Turabian StyleJiang, Xueqi, Beibei Miao, Xiaofei Zhao, Xuemei Bai, Min Yuan, Xia Chen, Xinyi Gong, Zeliang Liu, Jie Li, Shuang Meng, and et al. 2023. "Unveiling the Emergence and Genetic Diversity of OXA-48-like Carbapenemase Variants in Shewanella xiamenensis" Microorganisms 11, no. 5: 1325. https://doi.org/10.3390/microorganisms11051325
APA StyleJiang, X., Miao, B., Zhao, X., Bai, X., Yuan, M., Chen, X., Gong, X., Liu, Z., Li, J., Meng, S., Han, X., & Li, J. (2023). Unveiling the Emergence and Genetic Diversity of OXA-48-like Carbapenemase Variants in Shewanella xiamenensis. Microorganisms, 11(5), 1325. https://doi.org/10.3390/microorganisms11051325

